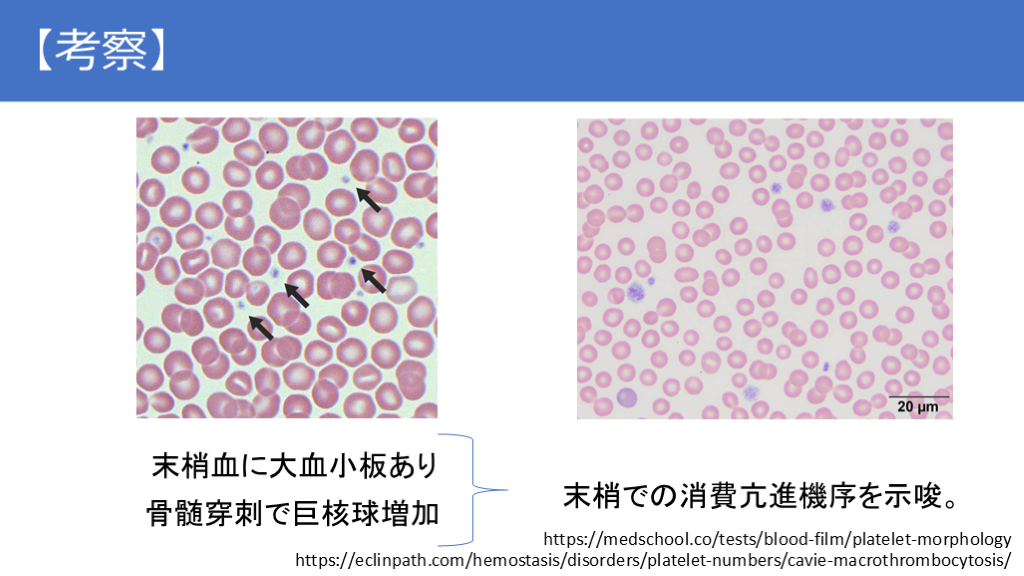

関連テーマから出会おう。
閲覧履歴からのおすすめ
1/76
関連するスライド
過敏性腸症候群に対するRifaximinの効果
G-MoreJournal Club
20530
14
研修医・専攻医向け!今さら聞けない 鼻副鼻腔炎診療 まとめ!
じびっこ@耳鼻咽喉科医
15994
82
病態生理で迫る臨床推論
30,144
48
投稿した先生からのメッセージ
なんとなくの90%当たる臨床推論ではなく、100%正しく患者さんのことを理解できることが大切だと思っています。
概要
以前外部のカンファレンスで発表した内容です。
長いですが内科医として最も大切な正しく考えるということを重視しています。
他の症例も全てこの考え方でしています。ご質問やコメント等ぜひお願いします。
本スライドの対象者
医学生/研修医/専攻医/専門医
投稿された先生へ質問や勉強になったポイントをコメントしてみましょう!
0 件のコメント
わかやまさんの他の投稿スライド
癌患者の感染症の基本
わかやま
12,668
43
病態生理で迫る臨床推論③(開口障害) なんとなくのキーワード診断から脱却するために
わかやま
8,745
18
【音声解説付き(全18分程度)】全ての内科医に知って欲しい内科診療の基本
わかやま
13,540
70
このスライドと同じ診療科のスライド
在宅医療から学ぶ意思決定のヒントースピリチュアルケア編
やまと診療所 AHC-ACADEMY OF HOME CARE-
2,554
5
在宅医療における患者さんの電話対応
やまと診療所 AHC-ACADEMY OF HOME CARE-
6,775
10
「在宅医療」で医師のキャリアはどう変わるのか?
やまと診療所 AHC-ACADEMY OF HOME CARE-
11,801
8
災害✕高齢者医療✕オンライン診療~オンライン診療で描く未来~
藤原翔
1,721
3
病棟管理の掟 カルテの書き方とチェックリスト
どてちん先生
33,392
281
一般外来や救急外来で役立つ!壊死性筋膜炎から深める感染症診療 〜広域抗菌薬の適切な使いどころと経過観察の心得〜
山口裕崇
109,169
329
テキスト全文
急性硬膜下血腫の症例と経過
#1.
一宮西病院 総合内科リウマチ膠原病内科 〜症例から学ぶ腹部膨満〜 若山 裕人 〜病態生理で紐解く/脱キーワード診断〜
#2.
【主訴】腹部膨満感 【既往歴】なし 【内服歴】なし 【現病歴】X/8/9までは健康で無症状。8/10から左側頭部痛出現。 徐々に右側にも広がり, 持続。8/17当院脳神経外科受診。頭部 CTで”急性硬膜下血腫”と診断され緊急入院となった。入院時体 重53.0kg。脳神経外科よりレベチラセタム1000mg/日, アムロジピン 5mg/日, アジルサルタン20mg/日, ロキソプロフェン 60mg/日投与 開始された。 【症例】
#3.
頭部CT 【入院後経過】
#4.
8/18, 8/19(入院後2日間)は頭痛が強く, 食事もとれない ほどであった。8/20から頭痛が軽減。この頃からトイレ以 外にも病棟内を点滴棒を支えにして歩行・リハビリ可能と なった。内血管造影をおこなったが血管奇形は見られなかった。 【入院後経過】
#5.
8/28から息が吸いづらく深吸気時や臥位で咳嗽が出現。 ベッドを起こして寝るようになった。この頃から腹部膨満感 あり。8/29からSPO2が92%であり、酸素投与2L開始。8/30 両下肢浮腫・尿量の減少に気づく。8/30から著しい全身倦 怠感あり、頭痛も増悪し終日ベッドで過ごすようになった。 9/1総合内科に転科となった。 【入院後経過】
身体診察と検査結果のまとめ
#6.
【生活歴】 三重県生まれ。父は長野県出身、母は三重県出身。海外旅 行は10年以上前行ったのみ。自宅で犬を飼育。 X年8月初旬に九頭竜湖でカヤックをした。ダニ、蚊など虫刺 されなし。外傷なし。 乾燥症状はなく、涙や唾液はよく出る。 【症例】47歳, 女性
#7.
BT 36.7℃, BP 148/93 mmHg, HR 78 回/分 SpO2 98%(room air), RR 20回/分 身長 164 cm 体重 63.7 kg 眼球結膜: 黄染なし、充血なし。 左鎖骨上に0.5cm程度の可動性良好で圧痛のないリンパ節 頸静脈拍動は胸骨角より4cm上 心音: リズム整, 心雑音なし 呼吸音:胸部で第8肋間以下で打診濁音、同部で清音振盪減弱し呼吸音低下 腹部: 軽度膨満, 軟, 軽度の圧痛あり, 打診時に疼痛あり 背部・両臀部・両下肢マットレスの硬さの圧痕性浮腫あり 【身体診察】内科専攻医が診察
#8.
脳神経:Ⅰ〜Ⅻ正 感覚:触覚正 痛覚正 位置覚正 運動:MMT5/5 筋トーヌス正 容積正 不随意運動なし 高次機能:見当識正 記憶正 反射(R/L):下顎- 上腕二頭筋+/+ 橈骨+/+ 上腕三頭筋+/+ 尺骨+/+ 膝-/- 踵+/+ 髄膜刺激兆候なし 【身体診察】内科専攻医が診察
#9.
【血液検査 X/8/17】脳外科入院日
#10.
【血液検査 X/9/1】内科転科日 APTT 49.3 秒 PT-INR 1.06 FDP 27.1 μg/ml Dダイマー 6.3 μg/ml HIV-Ab 陰性 アスペルギルス抗原陰性 βdグルカン陰性 血液培養2/2陰性
画像検査とその所見の解釈
#11.
【尿検査 X/9/1】 PH 5.0 蛋白 + 糖 - ウロビリノゲン +- ビリルビン - 尿比重 1.017 赤血球 1-4/HPF 白血球 1-4/HPF 扁平上皮 1-4/HPF 尿細管上皮<1/HPF 上皮円柱1-9/HPF 顆粒円柱1-9/HPF Na 20 mEq/dL Cl 15 mEq/dL Cr 168.2 mg/dL UA 28.2 mg/dL 尿蛋白/Cre 0.4 g/gCr FeNa 0.16 %
#12.
【12誘導心電図】X/8/17(脳外科入院時)
#13.
【胸部レントゲン】左8/17 右9/1
#14.
【頭部・胸腹部単純CT】左8/17 右9/1
#15.
【頭部・胸腹部単純CT】 9/1
入院後の経過と治療方針
#16.
【画像所見まとめ】 新規に胸腹水貯留(20HU) 門脈周囲にびまん性に低吸収あり 硬膜下血腫は縮小傾向 軟部組織に脂肪識濃度上昇あり 左鎖骨上に造影効果のある1cm程度のリンパ節
#17.
【入院後経過】 9/1からメロぺネム(MEPM)、ドキシサイクリン(DOXY)を 開始。9/1 経胸壁心エコー(TTE)施行。9/2 右胸腔穿刺 (850ml)、9/3 腹水穿刺(2000ml)を施行。腹水排液直後に、 呼吸苦と腹部膨満感は消失。翌日から毎日1kg程度の体 重増加を認め、呼吸苦と腹部膨満感も再度出現した。
#18.
【検査結果】 【胸水穿刺】X/9/2 淡黄色透明 臭無 TP 2.9(血 5.2) Alb 1.3(血 2.1) LD 87(血 252) 【TTE】X/9/1 WBC 89 ADA 6.9 細菌・抗酸菌培養陰性 セルブロック陰性 【腹水穿刺】X/9/3 淡黄色透明 無臭 TP 2.4 Alb 1.3 LD 80 WBC 65 細菌・抗酸菌培養陰性 セルブロックで異型細胞なし LVIDd 41 mm LVIDs 26 mm EF 66% 弁膜症なし TRPG 24.3 mmHg 疣贅を認めない IVC 6/7mmHg 呼吸性変動なし
#19.
【検査結果】 【骨髄穿刺】X/9/2 NCC 89000, 巨核球数 13, M/E 10.9, 芽球 3.5% フローサイトメトリー クローナリティのある細胞集団なし 【リンパ節生検】X/9/2 リンパ濾胞は萎縮し、濾胞間が開大。胚中心には tingible body macrophageあり。濾胞構造は正。濾胞間 には形質細胞が多数浸潤。 骨髄穿刺液の抗酸菌培養陰性
#20.
既往歴のない47歳女性の突然の頭痛で発症した急性硬膜下血腫。 血腫は消退傾向にも関わらず、全身倦怠感、胸腹水貯留・浮腫が進行し緩徐にCrが上昇。 胸腹水穿刺で一時症状は改善するが再度胸腹水は貯留。 左頸部に1cm程度の造影効果のあるリンパ節を認める。 【ここまでの簡単なまとめ】
鑑別診断と診断方法の考察
#21.
鑑別診断と診断方法は?
#22.
【血液検査】X/9/7 APTT 49.6 秒 PT-INR 1.15 FDP 27.1 μg/ml Dダイマー 6.3 μg/ml
#23.
【検査結果】 MPO-ANCA<1.0 PR3-ANCA<1.0 ツツガムシIgM/IgG陰性 抗SS-A抗体 16倍 抗SS-B抗体 陰性 TSPOT 陰性 【血液検査】 第2, 8, 9, 10 因子活性>100% 第13因子活性 28% 【骨髄生検】 鍍銀染色で細網線維増加。 軽度の骨髄線維化。異型細胞なし
#24.
9/11-プレドニゾロン(PSL) 50mg静注開始。9/14-シクロス ポリン 200mg/日で内服開始した。体重が徐々に減少し, 腹 部の膨満感も改善。9/20 体動で悪化する右腰痛が出現。 リハビリ中止。9/21 腹部造影CTで右腸腰筋内に5cm大の血腫 を認めた。 【入院後経過】
#25.
【入院後経過】
#26.
【事象】 47歳女性の非外傷性の硬膜下血腫 進行性の体液貯留と浮腫 緩徐進行性の血小板減少 鎖骨上のリンパ節腫脹 第13因子活性低下 高Cr血症
#27.
鑑別診断と診断方法は?
#28.
腔水症 血小板減少 高Cr血症 硬膜下血腫 【思考回路】 組み合わせで診断名を想起 その病気に当てはまる・当てはまらない推論 1つ1つの事象の分析が甘く、事実からかけ離れる
#29.
【思考回路】 野球ボールだとすると・・ テニスボールだとすると・・ 大きさ・形・重さ・硬さ等 この物質に関して分析
#30.
腔水症 血小板減少 高Cr血症 【思考回路】 1つ1つの事象の分析 毛細血管透過性 亢進 消費亢進性 硬膜下血腫 血小板減少 腎血流低下性 高Cr血症 易出血性 患者に何が起こっているか
診断の根拠と考察の整理
#31.
【診断とは】 ・診断は根拠事象を持って集合を右に進めていく作業。 血小板減少の集合の1例 ・集合は絶対的で互いに重複があってはならない。 ・集合はカテゴリーを意識して作成する。
#32.
【診断とは】 臨床内科学 診療講座 栗本 秀彦先生のホームページより
#33.
【診断とは】 臨床内科学 診療講座 栗本 秀彦先生のホームページより
#34.
【診断とは】 ・事実と解釈の分離を徹底的にする。 例1)胸部CTで2cm程度の腫瘍(解) 例2)骨髄穿刺で白血病細胞あり(解) ・解釈を事実として捉えているような記載の例。 2cm×2cmの境界明瞭・辺縁整・内部30HUの腫瘤(事) 細胞質が赤血球の2倍で薄い紫色で類縁形で核が細胞質の90%程度をしめ核小体が目立つ濃い紫色の細胞を認める(事)
#35.
【診断とは】 ・診断は病気を当てるゲームではない。 ・診断は患者の体に何が起こっているのかを正確に 把握すること。 ・原因に目が行きがちだが、結果として病気が人体 に何をきたしているのか考察が必要。
#36.
#1 非外傷性硬膜下血腫 #2 急性腔水症 #a 高Cr血症 #b 血小板減少症 #c 大臀筋血腫 【プロブレムリスト】 ※プロブレムリストは疾患の開始順とする
#37.
【考察】#2に関して 腔水症 ⊃静水圧上昇 ⊃血管透過性亢進(Capillary leak) ⊃膠質浸透圧低下
#38.
【考察】#2に関して 腔水症 ⊃静水圧上昇 ⊃血管透過性亢進(Capillary leak) ⊃膠質浸透圧低下 ・TTE:IVC 6/7mm →静水圧上昇機序を否定
#39.
【考察】#2に関して 腔水症 ⊃静水圧上昇 ⊃血管透過性亢進(Capillary leak) ⊃膠質浸透圧低下 ・TTE:IVC 6/7mm →静水圧上昇機序を否定 ・Albの低下より先に胸水が存在(8/17時点で少量の胸水あり)
#40.
【考察】#2に関して 腔水症 ⊃静水圧上昇 ⊃血管透過性亢進(Capillary leak) ⊃膠質浸透圧低下 ・TTE:IVC 6/7mm →静水圧上昇機序を否定 ・胸腹水の性状(蛋白, Alb)→滲出性胸腹水 ・分布(全身の浮腫・胸腹水) ・Albの低下より先に胸水が存在(8/17時点で少量の胸水あり) ・急速に進行する浮腫
高Cr血症の原因と考察
#41.
【考察】 根拠事象 ・胸腹水の性状(蛋白, Alb)→血管透過性亢進を示唆 ・分布(全身の浮腫・胸腹水)→血管透過性亢進を示唆 ・Albの低下より先に胸水が存在→膠質浸透圧低下を否定 ・急速に進行する浮腫→血管透過性亢進を示唆 ・TTE:IVC 6/7mm →静水圧上昇機序を否定
#42.
【考察】 #2 急性腔水症 → #2 Capillary leak symdrome
#43.
【考察】 Capillary leak symdrome ⊃感染(細菌・ウイルス・真菌・結核) ⊃自己免疫(MCD/TAFRO/SJS/SLE) ⊃腫瘍(リンパ腫) ⊃薬剤
#44.
【考察】 Capillary leak symdrome ⊃感染(細菌・ウイルス・真菌・結核) ⊃自己免疫(キャッスルマン TAFRO シェーグレン SLE) ⊃腫瘍(リンパ腫) ⊃薬剤 ・MEPM, DOXY無効 ・TSPOT, 抗酸菌培養陰性 ・ウイルス抗体陰性
#45.
【考察】 Capillary leak symdrome ⊃感染(細菌・ウイルス・真菌・結核) ⊃自己免疫(キャッスルマン TAFRO シェーグレン SLE) ⊃腫瘍(リンパ腫) ⊃薬剤 ・MEPM, DOXY無効 ・補体正, 抗核抗体陰性 ・TSPOT, 抗酸菌培養陰性 ・ウイルス抗体陰性 ・乾燥症状なし ・骨髄生検で細網繊維
#46.
【考察】 Capillary leak symdrome ⊃感染(細菌・ウイルス・真菌・結核) ⊃自己免疫(キャッスルマン TAFRO シェーグレン SLE) ⊃腫瘍(リンパ腫) ⊃薬剤 ・MEPM, DOXY無効 ・補体正, 抗核抗体陰性 ・TSPOT, 抗酸菌培養陰性 ・リンパ節, 骨髄生検でリンパ腫細胞なし ・ウイルス抗体陰性 ・乾燥症状なし ・骨髄生検 ・薬剤内服なし
#47.
【考察】 ・MEPM, DOXY無効。→一般細菌, リケッチア, レプトスピラ否定。 ・補体正、抗核抗体陰性→SLE否定。 ・抗SSA抗体低力価、乾燥症状なし→SJS否定。 ・リンパ節, 骨髄生検で異型細胞なし→リンパ腫否定 ・骨髄生検→TAFRO症候群を支持。 ・T-SPOT陰性、各種抗酸菌培養陰性→結核否定 根拠事象
#48.
高Cr血症 ⊃糸球体 ⊃間質 ⊃尿細管 ⊃腎動脈-細動脈(腎前性) 【考察】 ⊃腎盂-膀胱(腎後性)
#49.
高Cr血症 【考察】 ・赤血球円柱なし, 尿蛋白<3.0g/日 ・腎盂拡張なし ・尿中白血球陰性 ⊃糸球体 ⊃間質 ⊃尿細管 ⊃腎動脈-細動脈(腎前性) ⊃腎盂-膀胱(腎後性)
#50.
高Cr血症 【考察】 ・赤血球円柱なし, 尿蛋白<3.0g/日 ・腎盂拡張なし ・尿中白血球陰性 ⊃糸球体 ⊃間質 ⊃尿細管 ⊃腎動脈-細動脈(腎前性) ⊃腎盂-膀胱(腎後性) ・上皮円柱, 顆粒円柱あり ・FeNa<1.0
血小板減少のメカニズムと考察
#51.
【考察】 根拠事象 ・赤血球円柱なし, 尿蛋白<3.0g/日→糸球体疾患を否定 ・腎盂拡張なし→腎後性は否定的。 ・上皮円柱, 顆粒円柱→尿細管の傷害を示唆 ・FeNa<1.0→腎血流低下を示唆
#52.
【考察】 腎血流低下 ⊃hypovolemia ⊃血管病⊃攣縮⊃薬 ⊃運動 ⊃血栓⊃解離 ⊃炎症 ⊃塞栓
#53.
【考察】 腎血流低下 ⊃hypovolemia ⊃血管病⊃攣縮⊃薬 ⊃運動 ⊃血栓⊃解離 ⊃炎症 ⊃塞栓 ・補液で改善, IVC径 ・NSAIDS, ACE-I 造影所見より否定
#54.
【考察】 尿細管傷害 ⊃炎症 ⊃虚血 ⊃薬剤
#55.
【考察】 尿細管傷害 ⊃炎症 ⊃虚血 ⊃薬剤 ・尿中白血球なし ・腎血流低下が背景にあり ・尿細管障害の頻度の多い薬剤使用なし
#56.
【考察】 Capillary leakによる腎血流低下+薬剤 尿細管障害(虚血>>薬剤・炎症) +
#57.
【考察】 血小板減少 ⊃骨髄産生低下 ⊃末梢血で消費亢進 ⊃脾臓での分布異常
#58.
【考察】 ①血小板減少は本物か(偽性血小板減少症) ②血小板減少の起きた時期を確認 ③血小板以外の血球の減少の有無 ④脾腫の有無を確認 ⑤凝固異常の有無を確認 ⑥目視(大血小板、芽球、破砕赤血球の有無) ⑦骨髄中の巨核球の有無 血小板減少を見た時の確認事項 Up to dateから一部改変
#59.
【考察】 血小板産生増加の指標 骨髄穿刺での巨核球の数 末梢血血小板のサイズ +− MPV・幼若血小板比率 骨髄穿刺 World J Stem Cells 2019 September 26; 11(9): 565-721
#60.
【考察】 末梢での消費亢進機序を示唆。 末梢血に大血小板あり 骨髄穿刺で巨核球増加 https://eclinpath.com/hemostasis/disorders/platelet-numbers/cavie-macrothrombocytosis/ https://medschool.co/tests/blood-film/platelet-morphology
TAFRO症候群の診断と経過
#61.
【考察】 血小板減少 ⊃骨髄産生低下 ⊃末梢血で消費亢進 ⊃脾臓での分布異常 ・他血球の減少なし、巨核球減少なし ・脾腫なし ・大血小板あり ・急速な減少 ・巨核球増加
#62.
【考察】 末梢血での血小板消費亢進 ⊃感染(細菌・ウイルス) ⊃物理的破壊(人工物・ TMA・DIC) ⊃中毒(トキシン、薬剤) ⊃免疫性(ITP・SLE・HIT・TAFRO)
#63.
【考察】 末梢血での血小板消費亢進 ⊃感染(細菌・ウイルス) ⊃物理的破壊(人工物・ TMA・DIC) ⊃中毒(トキシン、薬剤) ⊃免疫性(ITP・SLE・HIT・TAFRO) ・抗菌薬無効(上述) ・体内に人工物なし ・目視で破砕赤血球なし ・ヘパリン使用なし ・抗核抗体陰性 ・血小板減少をきたす薬剤内服なし
#64.
【考察】 本症例はTAFRO症候群による血小板減少と結論
#65.
【考察】 血腫 ⊃局所の解剖学的な問題 ⊃易出血性
#66.
【考察】 血腫 ⊃局所の解剖学的な問題 ⊃易出血性 ・出血部位が数箇所にわたる ・特定の部位での出血
#67.
【考察】 易出血性 ⊃血小板の異常 ⊃凝固の異常 ⊃血管壁の異常
#69.
13因子欠乏に対してインヒビターを測定。インヒビターの存在はなし。 血管壁脆弱症の検索のためRumpel Leede試験を施行したが陰性であった。 【考察】
#70.
【考察】 易出血性 ⊃血小板の異常 ⊃凝固の異常 ⊃血管壁の異常 ・血小板低下あるが出血をきたすほどではない ・PT, APTT正、第13因子欠乏あり ・Rumpel Leede試験陰性 ・血小板の質は未評価
症例の最終的な結論と発表内容
#71.
【考察】 根拠事象 ・血小板の質の異常は未評価 ・PT, APTTの異常はなし。 ・第13因子の欠乏あり ・血小板は出血をきたすほどの数の異常はなし。 ・TAFRO症候群による血管炎の報告あり
#72.
【考察】 本症例は第13因子欠乏(Etiology 不明)もしくはTAFRO症候群によるVasculopathyと結論
#73.
#1 急性硬膜下血腫→急性硬膜下血腫(#3) #2 急性腔水症→TAFRO症候群 #3 続発性第13因子欠乏症 or Vasculopathy(#2) #a 高Cr血症→腎前性腎不全+ATN #b 血小板減少症→免疫性血小板減少症(#2) #c 大臀筋血腫→大臀筋血腫(#3) 【プロブレムリスト】 ※プロブレムリストは疾患の開始順とする
#74.
【その後の経過】 その後、全身倦怠感は消失。徐々に体重は減少し、胸腹水も 消失した。 10/26(プレドニン20m+タクロリムス200mg内服中)体重47.3kg, Plt:16.4万/μL, Cre:0.73mg/dL、CRP:0.03mg/dL。同日、退院。 外来で緩徐にPSL減量行い、X+1年9月14日にPSL終了と なった。X+1年10月19日に1週間前からの微熱、全身の浮 腫・体重増加を認め“TAFRO症候群”と診断した。 プレドニン増量も効果なく、トシリズマブ開始したところ著効し 退院となった。
#75.